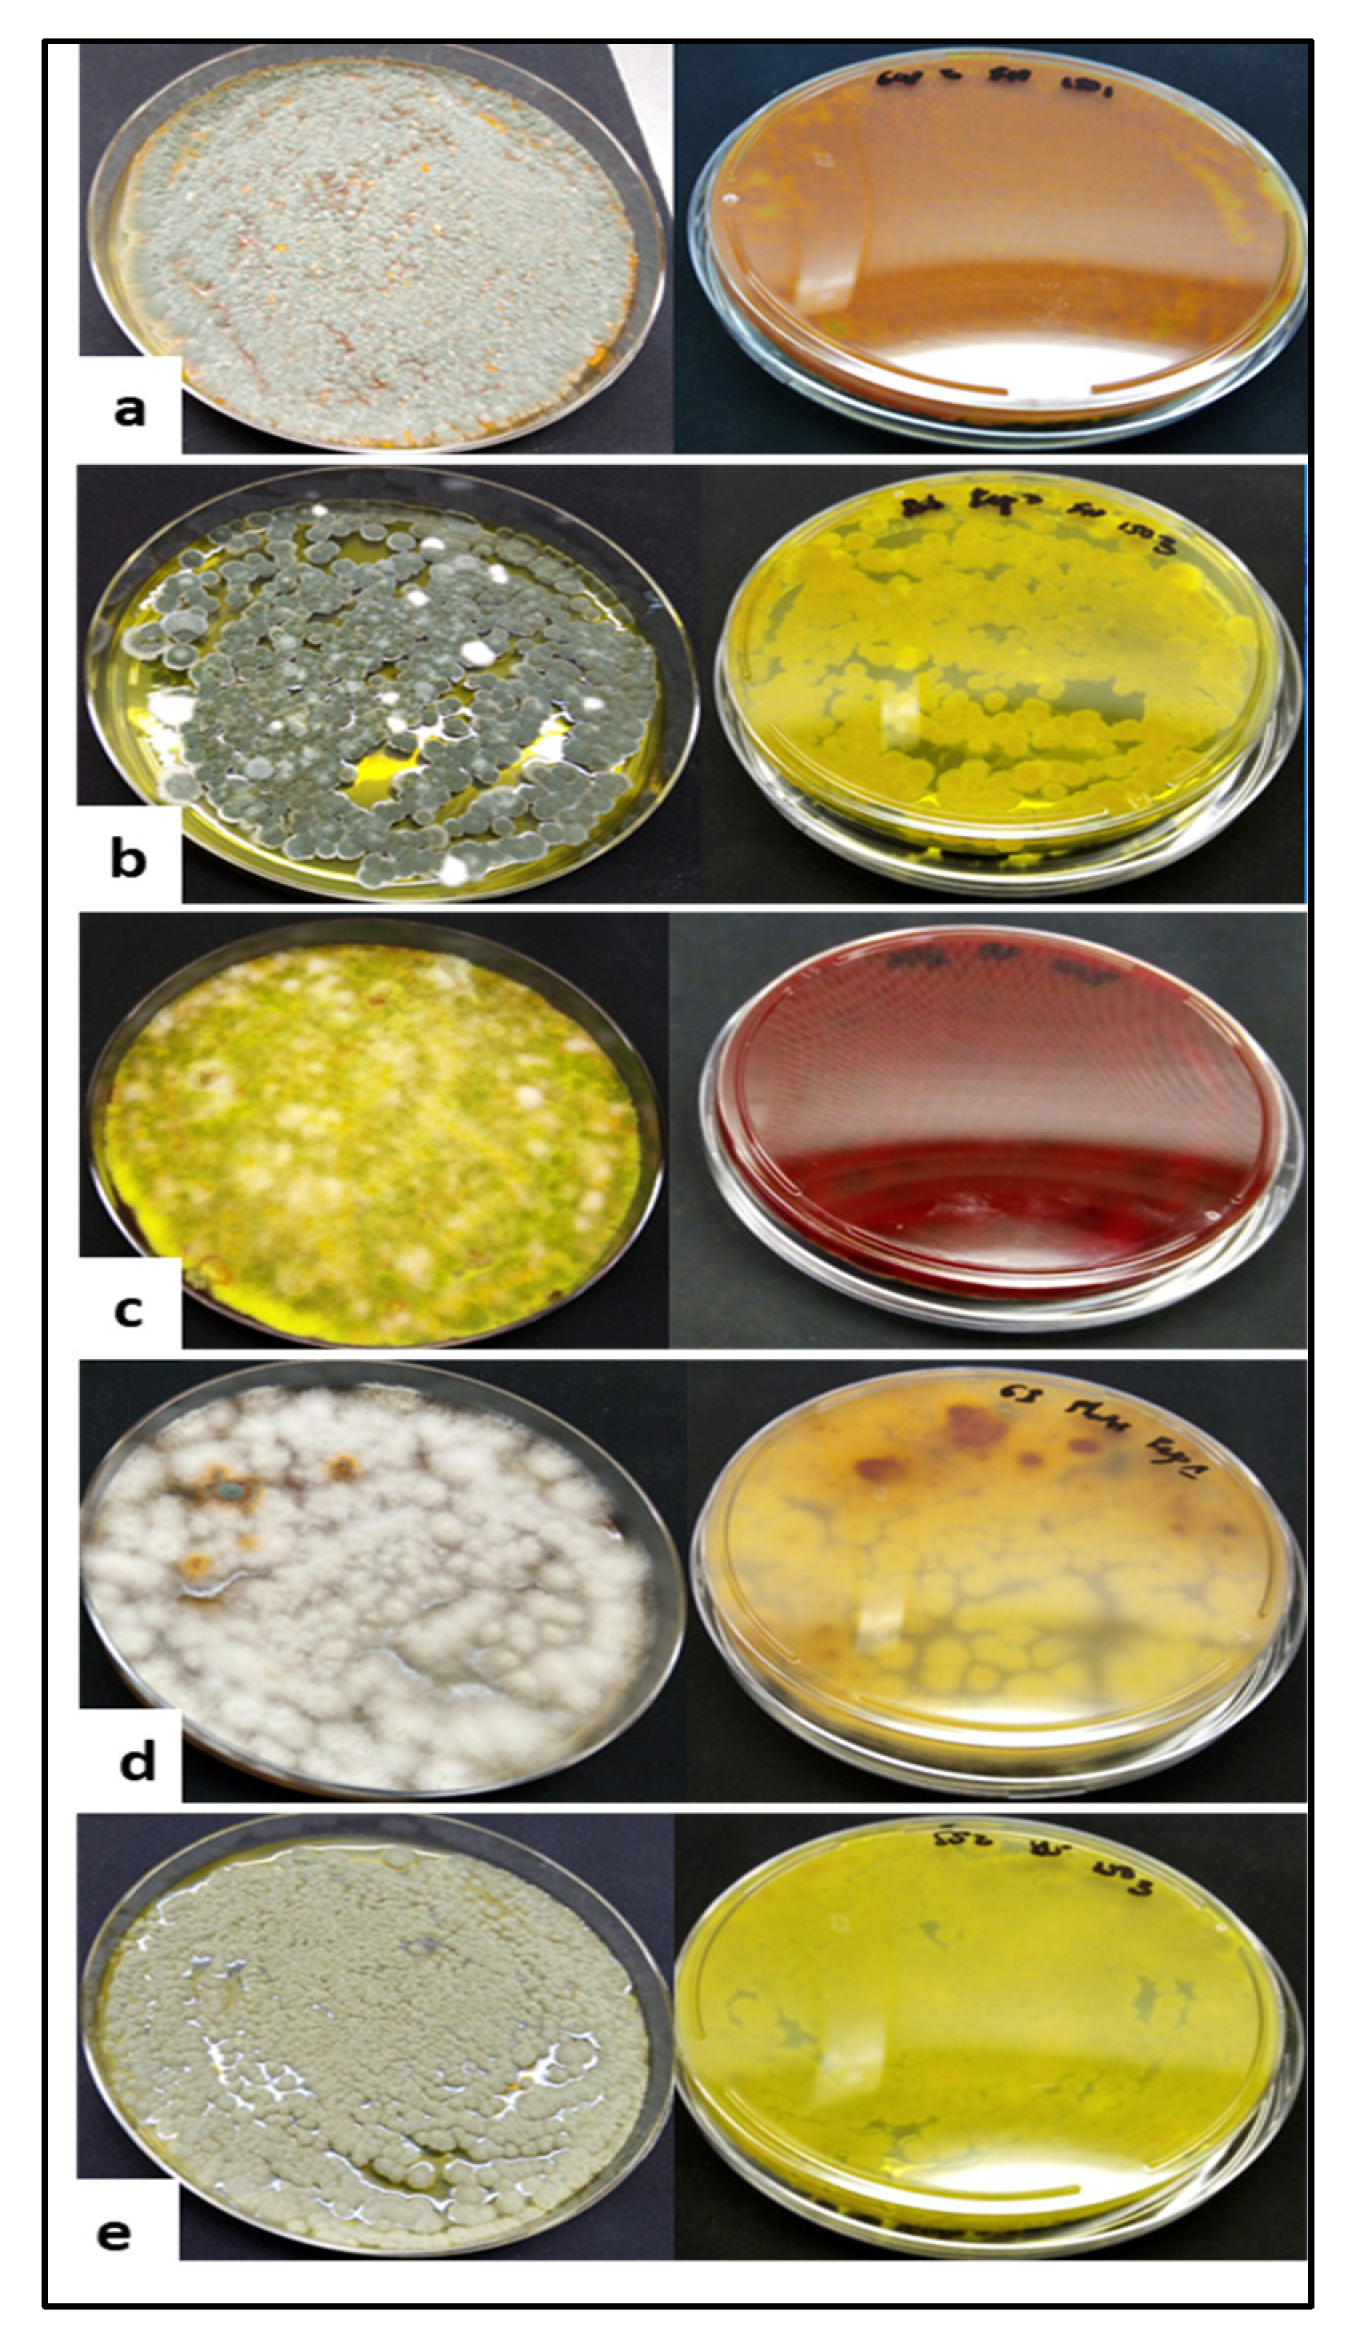
Fermentation 07 00295 g002

Abstract
The food and pharmaceutical industries are searching for natural colour alternatives as required by consumers. Over the last decades, fungi have emerged as producers of natural pigments. In this paper, five filamentous fungi; Penicillium multicolour, P. canescens, P. herquie, Talaromyces verruculosus and Fusarium solani isolated from soil and producing orange, green, yellow, red and brown pigments, respectively, when cultured on a mixture of green waste and whey were tested. The culture media with varying pH (4.0, 7.0 and 9.0) were incubated at 25 °C for 14 days under submerged and solid-state fermentation conditions. Optimal conditions for pigment production were recorded at pH 7.0 and 9.0 while lower biomass and pigment intensities were observed at pH 4.0. The mycelial biomass and pigment intensities were significantly higher for solid-state fermentation (0.06–2.50 g/L and 3.78–4.00 AU) compared to submerged fermentation (0.220–0.470 g/L and 0.295–3.466 AU). The pigment intensities were corroborated by lower L* values with increasing pH. The λmax values for the pigments were all in the UV region. Finally, this study demonstrated the feasibility of pigment production using green waste:whey cocktails (3:2). For higher biomass and intense pigment production, solid-state fermentation may be a possible strategy for scaling up in manufacturing industries.
1. Introduction
Fungi play an important role in the stability of terrestrial ecosystems, by acting as decomposers, recyclers and suppliers of nutrients [1,2]. They can be divided into three distinct substratum including saprobionts (saprophytes), parasites and symbiotic fungi [3]. The saprophytes participate in organic substrates (wood, dead plants and animals) decomposition [3]. Their significance is appreciated in the circulation of elements in nature, converting complex organic substances into simple inorganic compounds including nitrogen, phosphorus and potassium [3]. On the other hand, parasites are known to cause significant human and plant diseases [3] while symbiotic fungi are commonly used in pharmaceutical, biotechnological and food industries for the production of value added bio-molecules [4].
Considerable attention has been given to filamentous fungi able to produce colours of various shades including yellow, red, orange and green. These pigments fall in the sub-stratum of melanin, carotenoids or polyketides, with the polyketides instituting a larger portion of pigments normally produced by filamentous fungi [5,6]. They serve different physiological and ecological functions such as the protection (e.g., melanin) of the fungi against environmental stress [6], shielding from lethal oxidising radiation (e.g., carotenes) and as cofactors in enzyme catalysis (e.g., flavins) [7].
Food colouring is an important aspect that greatly affects the sensorial attributes of a given food commodity [8]. The Council of European Union (EU) has approved 43 dyes used as food additives, including 16 natural dyes, which have been assigned numerical identifiers with the letter E. However, in 2007 the European Parliament adopted a provision tightening the possibility of using some synthetic dyes. Many of the synthetic colourants used in sugary products and beverages include brilliant blue (E133), tartrazine (E102), quinolone yellow (E104), sunset yellow FCF (E110), carmoisine/azorubine (E122), ponceau 4R (E129) and allura red AC (E129) have restricted usage as sanctioned by the EU following scientific research proving their association with hyperactivity and attention deficiency in children [8]. The ever evolving food industry fuelled by the need for natural raw materials as well as consumer trends and awareness led to increased use of natural colour (e.g., carotene, chlorophyll, betaine and cochineal) ingredients in food. This is strengthened by the certainty that natural ingredients including colourants are better from a health perspective. In light of this, the food industry currently relies mostly on edible root tubers (carrots and beet), flowers and food by-products from food processing for colour extraction [9]. However, these raw materials are subject to environmental changes, which leads to variation in the shades of colours produced.
To these ends, fungi are well documented among the widely recognised pigment producing microorganisms and provide an alternative to synthetic colourants [10]. They grow independently of climatic conditions and can be cultured on a variety of agricultural substrates [11]. As far as the industrial production of fungal pigments is concerned, β-carotene and lycopene are the most common compounds being synthesised by Blakeslea trispora [12,13]. The production of such pigments involves culturing on expensive conventional media, which may deter sustainability. On the other hand, various industries of agricultural origin produce substantial amounts of wastes in forms of whey hydrolysates, skins, peels and seeds which are mainly considered as green waste [14]. These agro-processing residues can be used in the fermentation process to produce compounds of biological interest such as microbial single-cell protein as described by Kurcz et al. [15] and other microbial biomass as described by Kieliszek et al. [16] and other authors in the space of agro-industrial residue beneficiation [17,18]. In light of this, South Africa generates approximately 108 million tons of general waste (plastic, cartons, greens, glasses) annually, of which 98 million tons (90%) are disposed of at landfill sites, costing the municipalities about R1.7 billion South African State of Waste Report (SASWR) [19]. Therefore, it is important to effectively manage waste to save resources (water, land and energy) and also curb the production of greenhouse gas emissions, contributing to the attainment of the global sustainability goals (SDG 12 and 13).
Although the production of pigments using agro-industrial residues is documented [20,21], information regarding optimisation of pigment production looks at various strains of fungi cultured on green waste composites (consisting of carbon and nitrogen sources) is limited. In addition, the effect of media pH on the Chroma of pigment produced is also limited. Therefore, the current study describes the screening of filamentous fungi with pigment-producing abilities in relation to their application in the food industry. A more ecological approach of pigment production is emphasised via natural fermentation processes (submerged and solid states) using green waste as substrate coupled with the studying of quantitative colour descriptors based on CIE L*a*b* system plus the determination of Chroma (C*hab) on varying pH media.
2. Materials and Methods
2.1. Fungal Isolates
Pure fungi isolated from soil were obtained from the culture collection at the Department of Biotechnology and Food Technology (Tshwane University of Technology, Pretoria, South Africa). These isolates (100) were screened for pigment production. To increase the bio-prospection of pigmented fungi, additional soil samples were collected from four different provinces in South Africa [Gauteng; Moreleta Park Nature Reserve (25.8169° S, 28.2912° E), Limpopo; Pilanesberg (25.2403° S, 27.0758° E), Western Cape; Somerset West (34.0757° S, 18.8433° E) and Eastern Cape; Guano Caves (33.7749° S, 20.1224° E).
2.1.1. Culture and Purification of the Fungi from Additional Soil Samples
One gram (1 g) of each soil sample was obtained and dispensed in 9 mL of sterile quarter strength Ringer solution (Merk, Johannesburg, South Africa) to obtain a 10-fold serial dilution. An aliquot of each dilution (0.1 mL) was inoculated onto potato dextrose agar (PDA) (Merk, Johannesburg, South Africa). The inoculated plates were incubated at 25 ± 2 °C and the growth was observed daily for 7 days. Pigmented isolates were aseptically selected using a needle and purified by sub-culturing onto fresh PDA plates followed by a further 7 days incubation. Subsequently, the pure culture of pigment-producing fungi was preserved in sterile double strength Ringer solution (9 mL). The Ringer solution was poured onto each plate of pure fungal isolate and the mycelium bed was scraped using a sterile glass rod to harvest spores. The resultant spore solution was collected using a sterile syringe and dispensed into MacConkey bottles, which were stored at 4 °C until further use. In addition, the pure isolates were preserved using the PDA slant technique and incubated at room temperature for 7 days prior to storage at 4 °C.
2.1.2. Fungal DNA Extraction, Amplification and Sequencing
The genomic DNA of the isolates was extracted using the manufacturer’s protocol of the Quick DNA™ Fungal/Bacterial Mini-Prep Kit (Zymo Research, Inqaba Biotechnical Industries (Pty) Ltd., Pretoria, South Africa). The internal transcribes spacer (ITS) region of the DNA extracts was subsequently amplified using OneTaq® Quick Load® 2X Master Mix with 5′-TCCGTAGGTGAACCTGCGG-3′ and 5′-TCCTCCGCTTATTGATATGC-3′ primers for the small and large (ITS1 and ITS4) subunits respectively. The PCR products were run on 2% agarose gel followed by extraction with Zymo™ Gel DNA Recovery Kit (Zymo Research). The extracted fragments were sequenced for forward and reverse reactions (Nimagen BrilliantDye™ Terminator Cycle Sequencing Kit V3.1 BRD3 100/1000) and purified with a DNA sequencing clean up kit (Zymo Research, ZR-96 DNA Sequencing Clean-up Kit™, Inqaba Biotechnical Industries (Pty) Ltd., Pretoria, South Africa). The cleaned fragments were analysed on the ABI 3500xl genetic analyser (Applied Biosystems, Thermo Fisher Scientific, Inqaba Biotechnical Industries (Pty) Ltd., Pretoria, South Africa), the CLC Biomain Workbench v7.6 was used to analyse the ab1 file generated by the ABI 3500xl instrument.
2.1.3. Fungal Identification and Construction of Phylogenetic Tree
The sequences obtained were inserted into the basic local alignment search tool (BLAST) database of the National Center for Biotechnology Information (NCBI) to search for nucleotides. BLAST results yielding above 97% of the query sequence were considered the best identity of the respective isolate. Subsequently, a phylogenetic tree was constructed with the obtained sequences using the maximum likelihood method (MEGA. v.6). The strength of the phylogeny was tested using 1000 bootstraps.
2.2. Characterisation of Green Waste
In the study, the green wastes (pineapple, papaya and banana peels) (15 kg) and the whey (5 L) were obtained from a local fresh produce market and milk processing facility, respectively. The green waste was divided into a mix of three products (pineapple, papaya and banana peels) and stored frozen at −80 °C (Snijders, Holland) in three portions of 5 kg until further use, while the whey was stored only at −4 °C.
The frozen peels were placed on a tray and thawed at 4 °C, followed by drying at 80 °C in a dehydration unit until a constant weight was reached. Subsequently, each dried sample was divided into two working batches of 2.5 kg. An industrial food blender (Omniblend V) was used to reduce the particle size of dried green waste followed by sifting through a 212-μm sieve (US Standard Mesh No. 70). The sift flours were mixed in 1:1:1 ratios (pineapple, banana, papaya and peels, respectively), labelled accordingly and stored in a desiccator at ambient temperature until further use. The mixed green waste was then characterised in terms of moisture content (dry bases), total protein, pH, micro- and macro-elements and total sugar.
The moisture content of the green waste was determined gravimetrically using the Kern moisture balance (Kern MLB 50-3N) where 5 ± 0.1 g of sample was dried at 120 °C using infrared light until a constant weight was reached.
The protein content of the green waste was determined using the Dumas combustion method (AOAC 997.09) on a protein analyser (TruMac Leco, Stockport, Cheshire, UK).
The pH of the green waste sample was determined using a calibrated pH meter with a glass electrode at room temperature (Orion Star-A211, ThermoFisher Scientific, South Africa). A 5% (w/v) solution of the green waste sample was prepared, homogenised and allowed to stand for 10 min. Subsequently, the pH was ascertained in three successive measurements and recorded.
Micro and macro elements in the green waste were determined by, the Inductive Coupled Plasma-Mass Spectrometry (ICP-MS) instrument coupled to an autosampler (NexION® 350D, PerkinElmer Inc., Waltham, MA, USA) following a method described by Hailu et al. [22]. Prior to analyses, 30 g of green waste sample was dissolved in 3000 mL of distilled water in a Schott bottle. The sample was incubated at 4 °C overnight, which allowed the leaching of soluble nutrients. The green waste leachate was filtered through a Whatman no.1 paper filter. The leachate was stored in a 1000 mL Schott bottle at 4 °C until further use. Standards of potassium (K), zinc (Zn) and copper (Cu) were prepared ranging from 0–1000 mg/L for calibration curves. The standards were injected first followed by the leachate in three replicates in the instrument. The concentration of each element in the leachate was observed and recorded.
Finally, the total reducing sugar in the green waste sample was determined using the phenol-sulphuric acid method following a procedure described by Rovera et al. [23]. The leachate was diluted 50 times in distilled water. One millilitre (1 mL) of the leachate was dispensed into test tubes in triplicate, 1 mL of freshly prepared phenol (5%) and 5 mL of 99.9% sulphuric acid was added to each test tube. The resultant solution was mixed by swirling and incubated at 30 °C for 30 min. Subsequently, an aliquot sample from each test tube was obtained and transferred into a 96 wells micro-titre plate in triplicate. The absorbance of the samples was measured using a spectrophotometer at 520 nm (Helios Gamma, Cambridgeshire, UK). Standard solutions of glucose ranging from 1–5 mg/mL for calibration were prepared and measured in the same manner.
2.3. Submerged Fermentation
Two processing parameters were used to optimise pigment production using green waste, namely: pH and agitation speed following procedures previously described by Pratap et al. [24] with modifications. Green waste leachate (Section 2.2) was mixed with milk whey (Dairy shop, Pretoria, South Africa) to make a 3:2 (leachate:whey) working solution. The solution was divided into three sub-lots and the pH of each was adjusted to 4.0, 7.0 and 9.0 using either 0.1 M NaOH or 0.1 M HCl at room temperature. Fifty millilitres (50 mL) of each lot was dispensed in 250 mL Erlenmeyer flasks in duplicate. The flasks were sterilised at 121 °C for 15 min. Subsequently, 1 mL of 7 days old culture of five selected pigmented fungi was inoculated into the fermentation broth. The flasks were incubated at 25 ± 2 °C under agitated (150 rpm) and static conditions respectively for 14 days. After fermentation, the cultured broth was collected in 50 mL falcon tubes and centrifuged at 7830 rpm (Eppendorf, Centrifuge 5430 R, Hamburg) for 30 min at 15 °C. The supernatant was collected and the pellet was dried at 60 °C until a constant weight was reached to determine the biomass yield.
2.4. Solid State Fermentation
A procedure previously described by Gmoser et al. [25] was followed with minor modifications. A mass of 50 g wet green waste (ratio 1:1:1 of pineapple, banana and papaya peels) was placed into a 250 mL Erlenmeyer flask and the moisture content was adjusted to 30% (w/v) with whey. The pH of the green waste:whey (3:2) mixture was adjusted to 4, 7 and 9 respectively in duplicate at room temperature. The flasks were inoculated with 1 mL spore suspension and incubated for 14 days at 25 °C. Subsequently, the substrate and mycelium were obtained, the latter was aseptically peeled from the substrate and frozen at −80 °C (Snijders, Holland) in a petri dish overnight followed by 48 h freeze-drying (Telstar LyoQuest, Terrassa, Spain) The particle size of the freeze-dried samples were reduced with pestle and mortar and weighed followed by dispensing in 250 mL Erlenmeyer flask. The pigments were extracted by agitating the flasks with two volumes of 50 mL 80% ethanol for an hour in an incubator at 25 °C and 150 rpm. The crude extracts were placed in Falcon tubes and centrifuged at 7348 rpm (Eppendorf, Centrifuge 5430 R, Hamburg) for 30 min at 15 °C and the supernatant was collected using a syringe and filtered through a 0.45 µm cellulose filter into a collection ampule and stored under refrigeration until further use.
2.5. Enzyme Activity
In all cases, unless stated otherwise, the model media pH (agar-based) was adjusted to 6.5 before sterilisation to determine the presence of enzymes (α-amylase, cellulose and pectinase) by fungal isolates. It is noteworthy that the authors only determined the presence or absence of enzymes by fungal isolates but did not measure quantity. The fungal inoculum size was 0.1 mL on sterile plates with an incubation period of 10 days at 25 °C. For α-amylase and pectinase activities, the plates were flooded with iodine solution and incubated at room temperature for 3 h, while 2% aqueous Congo red was used for cellulase activity with the same incubation period. All excess iodine and Congo red solutions were removed and the presence of clear zones was measured using a 150 mm digital calliper (Absolute Digimatic-Mitutoyo Corp., Japan). The enzyme determination procedures followed were adopted and modified from Wang et al. [26].
2.5.1. Media Composition for α-Amylase Activity
Modified basal medium containing 1 g/L peptone, 1 g/L NH4NO3, 0.2 g/L MgSO4·7H2O, 0.2 g/L KCI, 0.9 g/L K2HPO4, 15 g/L agar (Merck, Johannesburg) and 1.0 g/L supplemented with starch was made up in distilled water.
2.5.2. Media Composition for Pectinase Activity
Modified basal medium containing 1.2 g/L Na2HPO4, 1 g/L NH4CI, 0.2 g/L MgSO4·7H2O, 0.5 g/L NaCI, 3 g/L KH2PO4, 15 g/L agar and 1 g/L supplemented with pectin (Sigma-Aldrich, Johannesburg, South Africa) as the source of pectin was made up in distilled water.
2.5.3. Media Composition for Cellulase Activity
Modified basal medium containing 1.0 g/L peptone, 1.0 g/L NH4NO3, 0.2 g/L MgSO4·7H2O, 0.2 g/L KCI, 3 g/L K2HPO4, 15 g/L agar and 1 g/L carboxymethyl cellulose (Sigma-Aldrich, Johannesburg, South Africa) was made up in distilled water.
2.6. Colour Measurements
The λmax of the pigment supernatants at the end of fermentation (Section 2.4 and Section 2.5) was determined by measuring absorbencies at 200–1000 nm using a spectrophotometer (Gamma Helios, Stockport, Cheshire, UK). The pigment intensities were measured at 400 nm expressed as absorbance units (AU). In addition, at the end of the fermentation, quantitative colour descriptors of each batch were determined using a Minolta Chroma Meter (Konica Minolta-CR-410, Osaka, Japan) based on the CIE L*a*b* system. Chroma (C*ab) and hue angles were calculated according to Equations (1) and (2), respectively:
Chromaab = [(a)2 + (b*)2]1/2
Hue angleab = tan−1(b*/a*)
2.7. Statistical Analysis
The datasets were subjected to a simple analysis of variance (one-way ANOVA). Subsequently, a Bonferroni corrected t-test was used to determine significant differences where the p-values are lower than 0.05.
3. Results and Discussion
3.1. Fungal Identities and Phylogenetic Tree
From the 100 pure fungal soil isolates obtained from the Department of Biotechnology and Food Technology culture collection, only two displayed the ability to produce extracellular pigment.
Table 1 displays isolated filamentous fungi with abilities to produce extracellular pigments.
Table 1.
ITS identity of fungi isolated from soil.
In addition, fifteen isolates were obtained from soil samples of Somerset, Guano Caves, Morelata Park Nature Reserve, Pilanesberg terrestrial areas. Filamentous fungi are used in many industrial processes to produce secondary bioactive metabolites such as vitamins, polysaccharides and pigments. Yakop et al. [27], has reported on the genera of fungi commonly isolated from soil, these included Aspergillus, Penicillium, Trichoderma and Fusarium. In this present study, six genera were obtained which comprised of Penicillium (8%, n = 9), Fusarium (2%, n = 2), Talaromyces (2%, n = 2), Wojnowiciella (0.9%, n = 1), Epicoccum (0.9%, n = 1), Phoma (0.9%, n = 1) and Metarhizium (0.9%, n = 1). Overall, samples from Somerset displayed diversity in the number of different genera obtained (Penicillium, Fusarium and Talaromyces). In addition, the Penicillium spp. isolated were ubiquitous, represented in soil samples from Somerset, Guano Caves, Pilanesberg and Morelata Park nature reserve, respectively. This was followed by Fusarium spp. obtained from Somerset and Guano Caves. In contrast, the Talaromyces spp. obtained were localised in Somerset soil samples, along with Phoma and Metarhizium spp., which were isolated from Morelata Park nature reserve and Pilanesberg respectively. Furthermore, a bigger proportion (82%) of the isolates have been identified with precision at the species level. The results obtained in this study are similar to the findings reported by Fouillaud et al. [28]. These authors reported on a diversity of pigmented fungi from La Reunion Island, highlighting the identification of pigmented fungi from hard substrates, which is similar to the soil samples used in this study. Furthermore, the diversity and clustering of isolates from different locations in South Africa are presented in Figure 1.
Figure 1.
Phylogenetic tree displaying clusters of isolated fungi with pigment-producing abilities.
In Figure 1, isolates from Somerset (Penicillium spp.) clustered together and represented approximately 75–85% similarities, which could be an indication of common ancestry. Isolate Metarhizium and Epicoccum from Pilanesberg and the Biotechnology and Food Technology culture collection showed a distant relationship with the other isolates. Finally, the isolates selected, using the shade of pigment and clustering on the phylogenetic tree are illustrated in Figure 2 below. Notably, Penicillium sp. (P. multicolor, P. canescens and P. herquie) had green mycelia with orange-brown, olive-green and yellow, respectively while T. verruculosus and F. solani had yellow and white mycelia, producing maroon-red and brown pigments, respectively.
Figure 2.
Selected fungal isolates with pigment-producing abilities on Potato dextrose agar (a) P. multicolor, (b) P. canescens, (c) T. verruculosus, (d) F. solani and (e) P. herquie.
Penicillium multicolour and Penicillium herquei produced brown to goldish pigments diffusing into the media. Similarly, the Talaromyces spp. produced intense soluble red pigments. Similar findings are reported by Venkatachalam et al. [5] where filamentous fungi sourced from marine ecosystems were identified, predominant species belonged to Penicillium, Talaromyces and Aspergillus. According to FoodDive [29], bright red, purple, green, blue and violet are considered important emerging colours while green, blue and violet are difficult to produce naturally. Therefore, P. multicolor, (orange-red), P. canescens (green), T. verruculosus (maroon-red), F. solani (orange-brown) and P. herquie (yellow) were selected for further pigment production. To the best of our knowledge, there are limited reports on pigment production using green substrates by P. multicolour, T. verruculosus, P. canescens, F. solani and P. herquie. Furthermore, strides have been undertaken in the colouring industry to produce a commercial red pigment (Aprink RedTM) similar to that produced by T. verruculosus. The pigment is produced by Penicillium oxalicum var. Armenia CCM 8242 grown on conventional media with the ability to accumulate up to 2.0 g/L anthraquinone after a 3 to 4 days incubation period [30].
3.2. Green Waste Characterisation
Following the physicochemical analysis of the green waste, the moisture content on a dry basis averaged 8.83%, while protein and sugar recorded 8.80% and 22.27% respectively. The initial substrate pH was at 4.85, the mineral composition was low for potassium (5.35 mg/L), copper (0.42 mg/L) and zinc (0.77 mg/L) while a high amount of calcium was recorded (52.79 mg/L). The latter could be attributed to the released Ca ions from kappa casein in the whey solution during cheese manufacture. According to Pratap et al. [24], micro- and macronutrients are important in biochemical pathways for the synthesis of bioactive compounds. It could be that the presence of K and Ca albeit in moderate quantities could be conducive for the production of pigments.
3.3. Enzyme Activity
Alpha-amylase, cellulose and pectinases are lytic enzymes that catalyse the hydrolysis of amylose, cellulose and pectin, respectively, into their smaller monomer units. Table 2 demonstrates the enzyme activities of the five fungal isolates. Very high enzyme production was observed for F. solani and P. herquie (α-amylase), T. verruculosus and F. solani (cellulose) and P. canescens (pectinase). However, only P. canescens and F. solani could produce all three enzymes.
Table 2.
Extracellular enzymes secreted by the selected fungi with pigment-producing abilities.
Finally, pectinase activity was absent for P. multicolour, T. verruculosus and P. herquie. Extracellular enzymes are significant in the metabolic and catabolic activities of selected fungi; their primary role is to breakdown complex substrates (carbohydrates and proteins) for easier assimilation of nutrients [25]. For the purpose of solid-state fermentation, the ability of the selected fungal isolates to produce extracellular enzymes would be beneficial. This is due to the complex green waste substrates comprising of banana, pineapple and papaya peels.
3.4. Submerged Fermentation for Pigment Production Using Green Waste and Whey Cocktail
In our preliminary studies in Figure 3, the impact of carbon source and pH as a changing variable was ascertained. The data obtained demonstrated that an increase of the pH from 4.0 to 9.0 lead to an increasing pigment intensity. This was expected as the effects of pH on the synthesis of pigments by fungal strains has been reported to be connected to the enzyme activity catalysing these reactions [31]. Unlike the natural pigments from plant sources (such as the anthocyanin) susceptible to fluctuating pH (leading to changed hue and intensity), the intensity of fungal pigments is connected with enzymes that catalyse their production, pH influences the functional activity of microbial enzymes the more conducive the environment the more favourable products are produced Gmoser et al. [32].
Figure 3.
Preliminary mycelial biomass and pigment intensities of fungal isolates cultured on green waste leachate as the sole source of carbon at pH 4, 7 and 9, agitation speed 90 and 150 rpm, temperature 15, 25 and 35 °C.
From Figure 3, it is apparent that pH affected pigment production. Higher pigment intensities were recorded at pH 7 and 9 with outlying cases for P. multicolour and P. canescens which had higher pigment intensities at pH 4 recording 0.8 and 0.25 absorbance units (AU) at 400 nm, incubation temperature of 35 °C and agitation speed of 90 rpm respectively. Furthermore, there is an inverse correlation between the biomass yield and pigment intensities for all selected isolates. The overall biomass yield was substantially lower than the intensity of extracellular pigments. According to Lebeau et al. [33] and Venkatachalam et al. [5], higher biomass yields are significantly important for fungal species that produce intracellular pigments. A study conducted by Joshi et al. [34] demonstrated the effect of apple pomace on biomass yield and pigment intensity by Sarcina sp. Their report postulates that a substrate high in carbon source was partially conducive for higher biomass and pigment yields with values of 10 g/L and 12 mg/100g (carotenoid), as opposed to media, supplemented with potassium nitrate where values of 12.93 g/L and 12.80 mg/100 g were recorded. These results are similar to the preliminary data obtained in this study. As previously illustrated in (Section 3.2) the green waste leachate is high in total reducing sugar serving as a carbon source than other nutrients. It is postulated that the incorporation of a nitrogenous source could substantially improve both biomass and pigment yields.
On the other hand, the effect of temperature and agitation also affected biomass and pigment intensities. Overall, higher biomass and pigment intensities were recorded at an agitation speed of 150 rpm and 25 °C for all isolates at pH 9, 7 and 4. According to a study conducted by Tangarini and Mishra [35] on the production of melanin by a soil isolate, optimal conditions were at pH 7.0–8.5, 25–30 °C and agitation speeds ranging from 140–180 rpm. Similar findings were reported by Usman et al. [36] on the production of orange pigment by a soil isolate.
Therefore, augmented parameters selected for further pigment production with whey hydrolysate were incubated at 25 °C and 150 rpm.
The optimal pH for pigment production in most fungal strains has been reported to range from 6.5 to 8.0 [16]. In this study, optimal production was recorded at pH 7.0 and 9.0. On the other hand, literature also reports that the relationship between C:N ratios influences the production of pigments in filamentous fungi. For instance, a high carbon content had a significant impact on pigment production as demonstrated by Pombeiro-Sponchiado et al. [37] in a study using Aspergillus chevalieri. A similar study as reported by Gmoser et al. [32] also recorded that the limitation of nitrogenous compounds in fermentation media increases pigment production particularly in M. purpureus strains and Fusarium spp. In light of these observations, conflicting data were recorded in our work with considerations of the substantial sugar content in the green waste as illustrated by the nutrient analysis (Section 3.2). Arianka et al. [20] reported findings similar to our work where Aspergillus carbonarius produced an approximated 3.8 AU/g in raw apple pulp and 9.2 AU in raw pomegranate. To overcome the limitation of lower pigment intensities using carbon sources alone, the incorporation of whey as a protein source was evaluated in the subsequent experiments. The biomass and pigment intensities using green waste:whey cocktails is illustrated in Figure 3 at agitated conditions.
As recorded in Figure 4, there was a substantial increase in biomass and pigment intensities for all isolates. Approximately 10-fold increase (averaging 0.220–0.470 g/L and 0.295–3.466 AU) is observed for biomass and pigment intensities in relation to green waste media (data not shown) (which averaged 0.013–0.210 g/L and 0.086–0.761 AU). As previously stated, the effect of pH was also the same in this instance. Overall, there was a correlation with increasing pH, higher pigment intensities were observed at pH 7 and 9. This observation suggests that for the selected isolates, acidic pH was not conducive resulting in reduced pigment production while neutral and alkaline pH were more favourable for the production of intense pigments. This observation is conflicting with what is reported in the literature that the majority of filamentous fungi produces pigments as result of stress responses [14,32]. On the other hand, it can be postulated that the incorporation of whey hydrolysate had a positive impact on biomass yield and pigment intensities. According to Gmoser et al. [32], the incorporation of soluble nitrogen sources (especially amino acids) favours the excretion of extracellular pigments. Typically, whey proteins are found in solution [37], which could have contributed to the increased intensity of extracellular pigment synthesis.
Figure 4.
Mycelial biomass and pigment intensities of selected fungi on green waste supplemented with whey protein using submerged fermentation (SmF) method, categories with different letter superscript showed significant differences p ≤ 0.05.
3.5. Solid State Fermentation Using Green Waste and Whey Cocktail
Figure 5 illustrates biomass and pigment intensities of selected fungi under solid-state fermentation. Juxtaposing the two fermentation methods (submerged versus solid-state), there was a significant increase in both biomass and pigment intensities for solid-state fermentation with values ranging 0.06–2.50 g/L and 3.78–4.00 AU for biomass and pigment intensity, respectively. The hydrolysis of the green waste substrate by fungal enzymes (amylase, cellulase and pectinase) coupled with the provision of soluble protein by the whey could have led to substantial assimilation of nutrients leading to higher biomass and intense pigmentation.
Figure 5.
Mycelial biomass and pigment intensities of selected fungi on green waste supplemented with whey protein using the solid-state fermentation (SSF) method, categories with different letter superscript showed significant differences p ≤ 0.05.
Biomass production was significantly lower than the pigment intensity at pH 4 and 7 when using the solid-state method, except for P. herquie at pH 7. For P. multicolor and F. solani at pH 7, the biomass was substantially lower than at pH 4 and 9, this observation could be attributed to stunning growth affecting mycelial development. For all the isolates, biomass production was higher at pH 9. According to Lebeau et al. [33] and Venkatachalam [5], higher biomass yields are significantly important for fungal species that produce intracellular pigments, this is mainly due to the encapsulation of pigments in mycelial bodies, higher mycelial bodies correlate with higher pigment yield or intensities. This is similar to the findings made in this study where the intracellular accumulation of intense pigments occurred in solid-state fermentation as illustrated in Figure 6.
Figure 6.
Selected fungal isolates were grown on green waste and whey cocktail media at pH 4, 7 and 9.
Finally, apart from the media and process optimisation techniques used for pigment production in fungi, other novel promising techniques such as Clustered Regularly Interspaced Short Palindromic Repeats (CRISPR) have evoked scientific interests where the genetic make-up of microorganisms is altered to produce molecules of biological interest. This tool could be very useful in fungi with considerations that some of the filamentous fungi pigments are produced alongside mycotoxins which may deem them as a hazard for human and animal health. In light of this, Nielson et al. [38] successfully created a system for Aspergillus nidulans, harbouring the CRISPER-Cas9 system with potential application in various fungal systems with close to no adaptation. Corollary to this, the same authors’ demonstrated the effectiveness of the CRISPER-Cas9 system in Talaromyces atroroseus considered as a major natural red colour producer in the food industry. Notwithstanding these amazing achievements, gene editing in filamentous fungi for pigment production is still considered a growing area of research therefore more studies need to be conducted to establish conclusive data sets.
3.6. Colour Measurements
Figure 7, gives the colour indexes L*a*b*, the hue angles and Chroma values of pigments produced submerged and solid-state fermentation by the five selected fungal isolates at pH 4, 7 and 9 respectively. According to Wheltze [39], the L* measures lightness vs. darkness where values (0–50) are considered dark and (51–100) are light. Further, the a* measures red vs. green, a positive value indicates red whereas a negative one indicates green. Finally, the b* measures the relation between yellow and blue, similarly, a positive value indicates yellow and a negative one blue.
Figure 7.
Colorimetric descriptors of pigments by fungal isolates grown on green waste and whey cocktail media at pH 4, 7 and 9 using submerged and solid-state fermentation methods.
The pigments obtained had maroonish, green, red, brown and yellowish colours for isolates P. multicolor, P. canescens, T. verruculosus, F. solani and P. herquie, respectively, as illustrated in Figure 2 (Section 3.1). The recorded hues angles for the produced pigments ranged from 60.56–73.45, 14.29–62.39, 61.57–84.21, 74.32–77.50 and 69.05–81.72 for P. multicolor, P. canescens, T. verruculosus, F. solani and P. herquie, respectively. The data obtained is similar to that reported Lebeau et al. [33] According to these authors, the hue angle is defined as starting at the +a* axis and is expressed in degrees. This translates to 0° being +a* (red), while 90° would be +b* (yellow), similarly 180° denotes −a* (green) and finally 270° would be −b* indicative of blue. In light of this, pigments produced by submerged and solid-state methods in our study had hue angles at the borderline of 0° and 90°, the lowest being 14.29° for P. canescens and highest 81.72° for P. herquie. This is indicative of the colour tone of respective pigments, it could be postulated that the majority of the pigments are constituted by yellowish compounds and some with reddish compounds albeit in smaller quantities particularly for P. multicolour and T. verruculosus.
On the other hand, there was an inverse correlation with the lightness of pigments produced, i.e., lightness (L*) decreased with increasing pH for both fermentation methods with sporadic cases where irregularity was recorded particularly for P. canescens and P. herquie at solid-state fermentation. Similarly, the red index (a*) was higher (3.50–14.06 and 7.97–13.28) at submerged and solid-state conditions with increasing pH (7.0 and 9.0) for P. multicolor and (2.29–15.27 and 5.08–9.48) for T. verruculosus also at submerged and solid-state conditions. These findings are also similar to those previously reported by Lebeau et al. [31] where a marine isolate of Talaromyces spp. and terrestrial isolate of Penicillium purpurogenum rubisclerotium both producing red pigments were cultured in Defined Minimal Media broth (DMD) recording +a* values ranging from 10.8–13.4 and 0.7–0.9, respectively. However, the converse was true when these isolates were cultured in Potato Dextrose Broth (PDA), recording a staggering 63.8–65.8 and 49.9–51.5 respectively. Interestingly, a media constituted mainly of carbon sources promoted the production of intensely coloured red pigments. This observation contravenes our findings in preliminary studies (data not shown) as initial experiments included culturing of fungal isolates on green waste high with sugar content. From this, we can postulate that the biochemical pathways of fungal pigment production are still to be understood.
Furthermore, the yellow index (b*) was notably higher for isolates P. multicolour, P. canescens and F. solani ranging from 11.87–21.03, 5.14–23.11 and 5.90–28.65, respectively. The recorded chromaticity for all isolates ranged from 14.29–23.14. According to Wheltze [39], the saturation i.e., vividness or dullness of a given colour increasing outwards the centre plane. In this study, the average values for chromaticity are localised around the centre plane. This demonstrates that the pigments produced are not bright colours which also correlates with the overall L* values being below 50 with increasing pH.
Finally, the absorbance spectrum for the selected isolates is given in Table 3 and Figure 8. The majority of the pigments had a lambda max with higher absorbance in the UV region (200–400) although other absorbance(s) were recorded in the visible region (>400).
Table 3.
Spectra of pigments by selected isolates at UV and visible regions.
Figure 8.
Spectral distribution and lambda max of pigments by selected fungi.
According to the literature [40,41], most of the reported microbial pigments have maximum absorbance in the UV region. A few absorb in the visible region and this is could be due to the number of functional groups in the pigment.
4. Conclusions
A total of 14 pigmented fungi were obtained and identified at the species level. These fungi belonged to six genera i.e., Penicillium, Fusarium, Talaromyces, Wojnowiciella, Epicoccum and Phoma. All pigmented fungi were isolated from soil indicating that undisturbed soils can be a valuable source for the isolation of organisms with biological importance. Green waste used contained substantial amounts of sugar and micronutrients. The green waste and whey mixture was subjected to fermentation by five pigment-producing isolates. Under optimised conditions (pH 7.0–9.0) using submerged and solid-state fermentation modes, the green waste: whey cocktail were an effective substrate for pigment production posing it as an ecofriendly and economic strategy. The effect of media acidity/basicity had an impact on biomass and pigment intensities, higher biomass and intensities were recorded at pH 7.0 and 9.0 while acidic pH impaired biomass and pigment development. Along similar lines, the hue angles and chromaticity indicated that the pigments produced are dark, corresponding to the lower L* colour index which decreased with increasing pH. As the marketplace for fungal and bacterial pigment products is large for eventual applications, the current data demonstrate that further research is needed to confirm the chemical makeup, potential toxicity as well as bioactive activities of the pigments produced by the selected fungi. Ultimately, the aim will be to upgrade their overall production volume to meet the market demands by using several biotechnological tools, such as genome shuffling and fermentation strategies to scale-up production to industry level etc.
Author Contributions
Conceptualisation, T.B.J.M. and T.R.; Formal analysis, T.B.J.M.; Funding acquisition, T.B.J.M. and T.R.; Investigation, T.B.J.M.; Methodology, T.B.J.M.; Project administration, T.B.J.M. and T.R.; Resources, T.R. and W.A.; Supervision, T.R., L.S.d.S. and W.A.; Writing—original draft, T.B.J.M.; Writing—review and editing, T.B.J.M., T.R., L.S.d.S. and W.A. All authors have read and agreed to the published version of the manuscript.
Funding
This research received no external funding.
Institutional Review Board Statement
Not applicable.
Informed Consent Statement
Not applicable.
Data Availability Statement
Data presented in this study is part of the PhD thesis of MR Molelekoa and can be made available in consultation with the corresponding author and the main supervisor.
Acknowledgments
The authors would like to appreciate the financial support by the Tshwane University of Technology, the Tiso Foundation and the National Research Foundation (South Africa) Free Standing Doctoral Scholarship (Grant number: 112863) which enabled us to meet the research objectives carried out in this study.
Conflicts of Interest
The authors declare there is no conflict of interest that could emanate from the publication of this manuscript.
References
- Bielčik, M.; Aguilar-Trigueros, C.A.; Lakovic, M.; Jeltsch, F.; Rillig, M.C. The role of active movement in fungal ecology and community assembly. Mov. Ecol. 2019, 7, 36. [Google Scholar] [CrossRef]
- Olicón-Hernández, D.R.; González-López, J.; Aranda, E. Overview on the Biochemical Potential of Filamentous Fungi to Degrade Pharmaceutical Compounds. Front. Microbiol. 2017, 8, 1792. [Google Scholar] [CrossRef] [PubMed]
- Perlin, M.H.; Andrews, J.; Su San, T. Chapter Four: ABC and MFS Transporters and Their Roles in Survival and Pathogenicity. In Essential Letters in the Fungal Alphabet; Friedmann, T., Dunlap, J.C., Goodwin, S.F., Eds.; Academic Press: Cambridge, MA, USA, 2014; Volume 85, pp. 201–253. [Google Scholar]
- Werner, G.D.A.; Kiers, T. Friends in Fungi. 2012. Available online: https://science.sciencemag.org/content/sci/337/6101/1452.1.full.pdf?casa_token=GlztZ81gCGMAAAAA:o-Q3Wiz-WOXMJmiQtriQ9fcwMKH6WNJCImel6HixqdP67QsRru0O9WK2oEUKvWT_QWoasw2X496G (accessed on 25 August 2021).
- Venkatachalam, M.; Zelena, M.; Cacciola, F.; Ceslova, L.; Girard-Valenciennes, E.; Clerc, P.; Dugo, P.; Mondello, L.; Fouillaud, M.; Rotondo, A.; et al. Partial characterization of the pigments produced by the marine-derived fungus Talaromyces albobiverticillius 30548. Towards a new fungal red colorant for the food industry. J. Food Compos. Anal. 2018, 67, 38–47. [Google Scholar] [CrossRef]
- Lagashetti, A.C.; Dufossé, L.; Singh, S.K.; Singh, P.N. Fungal Pigments and Their Prospects in Different Industries. Microorganisms 2019, 7, 604. [Google Scholar] [CrossRef] [PubMed] [Green Version]
- Spiteller, P. Chemical ecology of fungi. Nat. Prod. Rep. 2015, 32, 971–993. [Google Scholar] [CrossRef]
- Sezgin, A.; Sibel, A. Food Additives: Colorants. 2017. Available online: https://www.researchgate.net/publication/322404775_Food_Additives_Colorants (accessed on 29 July 2021).
- Mansour, R.; Yusuf, M. Natural Dyes and Pigments: Extraction and Applications. In Handbook of Renewable Materials for Coloration and Finishing; Scrivener Publishing LLC: Beverly, MA, USA, 2018; pp. 75–102. [Google Scholar]
- Hoeksma, J.; Misset, T.; Wever, C.; Kemmink, J.; Kruijtzer, J.; Versluis, K.; Liskamp, R.M.J.; Boons, G.J.; Heck, A.; Boekhout, T.; et al. A new perspective on fungal metabolites: Identification of bioactive compounds from fungi using zebrafish embryogenesis as read-out. Sci. Rep. 2019, 9, 17546. [Google Scholar] [CrossRef] [PubMed] [Green Version]
- Panesar, R. Bio-utilization of Kinnow waste for the production of biopigments using submerged fermentation. Indian J. Nat. Prod. Resour. 2014, 3, 6. [Google Scholar]
- Finkelstein, M.; Huang, C.-C.; Byng, G.S.; Tsau, B.-R.; Leach, J. Blakeslea Trispora Mated Culture Capable of Increased be-ta-carotene Production. U.S. Patent 5,422,247, 6 June 1995. [Google Scholar]
- Xu, F.; Yuan, Q.-P.; Zhu, Y. Improved production of lycopene and β-carotene by Blakeslea trispora with oxygen-vectors. Process. Biochem. 2007, 42, 289–293. [Google Scholar] [CrossRef]
- Kurcz, A.; Błażejak, S.; Kot, A.M.; Bzducha-Wróbel, A.; Kieliszek, M. Application of Industrial Wastes for the Production of Microbial Single-Cell Protein by Fodder Yeast Candida utilis. Waste Biomass-Valorization 2018, 9, 57–64. [Google Scholar] [CrossRef] [Green Version]
- Kieliszek, M.; Piwowarek, K.; Kot, A.M.; Pobiega, K. The aspects of microbial biomass use in the utilization of selected waste from the agro-food industry. Open Life Sci. 2020, 15, 787–796. [Google Scholar] [CrossRef]
- O’Shea, N.; Ktenioudaki, A.; Smyth, T.; Mcloughlin, P.; Doran, L.; Auty, M.; Arendt, E.; Gallagher, E. Physicochemical assessment of two fruit by-products as functional ingredients: Apple and orange pomace. J. Food Eng. 2015, 153, 89–95. [Google Scholar] [CrossRef]
- Dufossé, L. Microbial Production of Food Grade Pigments. Food Technol Biotech. 2006, 44, 313–321. [Google Scholar]
- Benavente-Valdésa, J.R.; Aguilara, C.; Contreras-Esquivela, J.C.; Méndez-Zavalab, A.; Montañez, J. Strategies to enhance the production of photosynthetic pigments and lipids in Chlorophycae species. Biotechnol. Rep. 2016, 10, 117–125. [Google Scholar] [CrossRef] [Green Version]
- Department of Environmental Affairs. South Africa State of Waste. A Report on the State of the Environment. Final Draft Report; Department of Environmental Affairs: Pretoria, South Africa, 2018; 112p. [Google Scholar]
- Arikan, E.B.; Canli, O.; Caro, Y.; Dufossé, L.; Dizge, N. Production of Bio-Based Pigments from Food Processing Industry By-Products (Apple, Pomegranate, Black Carrot, Red Beet Pulps) Using Aspergillus carbonarius. J. Fungi 2020, 6, 240. [Google Scholar] [CrossRef]
- Babitha, S.; Soccol, C.R.; Pandey, A. Effect of stress on growth, pigment production and morphology of Monascus sp. in solid cultures. J. Basic Microbiol. 2007, 47, 118–126. [Google Scholar] [CrossRef] [PubMed]
- Hailu, S.L.; McCrindle, R.I.; Seopela, M.P.; Combrinck, S. Speciation of major and trace elements leached from coal fly ash and the kinetics involved. J. Environ. Sci. Heal. Part A 2019, 54, 1186–1196. [Google Scholar] [CrossRef] [PubMed]
- Rovera, M.R.; Johnston, P.A.; Lamsal, B.P.; Brown, R.C. Total water-soluble sugars quantification in bio-oil using the phenol–sulfuric acid assay. J. Anal. Appl. Pyrol. 2013, 104, 194–201. [Google Scholar] [CrossRef]
- Pratap, A.; Kumar, M.; Sibi, G. Fruit and Vegetable Waste Hydrolysates as Growth Medium for Higher Biomass and Lipid Production in Chlorella vulgaris. J. Environ. Manage. 2017, 4, 204–210. [Google Scholar]
- Gmoser, R.; Sintca, C.; Taherzadeh, M.; Lennartsson, P.R. Combining submerged and solid state fermentation to convert waste bread into protein and pigment using the edible filamentous fungus N. intermedia. Waste Manag. 2019, 97, 63–70. [Google Scholar] [CrossRef]
- Wang, W.; Li, Y.; Wang, H.; Zu, Y. Differences in the Activities of Eight Enzymes from Ten Soil Fungi and Their Possible In-fluences on the Surface Structure, Functional Groups, and Element Composition of Soil Colloids. PLoS ONE 2014, 9, e111740. [Google Scholar]
- Yakop, F.; Taha, H.; Shivanand, P. Isolation of Fungi from Various Habitats and their Possible Bioremediation. Curr. Sci. 2019, 116, 733. [Google Scholar] [CrossRef]
- Fouillaud, M.; Venkatachalam, M.; Llorente, M.; Magalon, H.; Cuet, P.; Dufossé, L. Biodiversity of Pigmented Fungi Isolated from Marine Environment in La Réunion Island, Indian Ocean: New Resources for Colored Metabolites. J. Fungi 2017, 3, 36. [Google Scholar] [CrossRef] [PubMed]
- FoodDive: Why Are Natural Colours Poised to Pop in 2021? Available online: http://www.fooddive.com/news/why-natural-colours-are-poised-to-pop-in-2021/591608 (accessed on 29 July 2021).
- Yanis, C.; Fouillaud, M.; Philippe, L.; Dufossé, L. Natural Hydroxyanthraquinoid Pigments: Current Situation and Future Op-Portunities in Food. Pigments in Food VII. 2013. Available online: Re-searchgate.net/publication/258553667_Natural_hydroxyanthraquinoid_pigments_current_situation_and_future_opportunities_in_food (accessed on 16 November 2021).
- Künzler, M. How fungi defend themselves against microbial competitors and animal predators. PLOS Pathog. 2018, 14, e1007184. [Google Scholar] [CrossRef] [PubMed]
- Gmoser, R.; Ferreira, J.A.; Lennartsson, P.R.; Taherzadeh, M.J. Filamentous ascomycetes fungi as a source of natural pigments. Fungal Biol. Biotechnol. 2017, 4, 1–25. [Google Scholar] [CrossRef] [Green Version]
- Lebeau, J.; Petit, T.; Clerc, P.; Dufossé, L.; Caro, Y. Isolation of two novel purple naphthoquinone pigments concomitant with the bioactive red bikaverin and derivates thereof produced by Fusarium oxysporum. Biotechnol. Prog. 2019, 35, e2738. [Google Scholar] [CrossRef] [Green Version]
- Joshi, V.K.; Rana, N.S. Optimization of apple pomace based medium and fermentation conditions for pigment production by Sarcina sp. Indian J. Nat. Prod. Resour. 2011, 2, 421–427. [Google Scholar]
- Tarangini, K.; Mishra, S. Production of melanin by soil microbial isolate on fruit waste extract: Two step optimization of key parameters. Biotechnol. Rep. 2014, 4, 139–146. [Google Scholar] [CrossRef] [Green Version]
- Usman, H.M.; Farouq, A.; Baki, A.; Abdulkadir, N.; Mustapha, G. Production and characterization of orange pigment produced by Halophilic bacterium Salinococcus roseus isolated from Abattoir soil. J. Microbiol. Exp. 2018, 6, 238–243. [Google Scholar] [CrossRef] [Green Version]
- Coultate, T.P. Food: The Chemistry of Its Components, 6th ed.; The Royal Society of Chemistry: Cambridge, UK, 2016. [Google Scholar]
- Nielsen, J.C. Development of fungal cell factories for the production of secondary metabolites: Linking genomics and metabolism. Synth. Syst. Biotechnol. 2017, 2, 5–12. [Google Scholar] [CrossRef]
- Wheltze, M. Measuring Color Using Hunter L, a, b versus CIE 1976 L*a*b*. 2016. Available online: https://www.hunterlab.com/media/documents/duplicate-of-an-1005-hunterlab-vs-cie-lab.pdf (accessed on 25 April 2020).
- Pombeiro-Sponchiado, S.R.; Sousa, G.S.; Andrade, J.C.R.; Lisboa, H.F.; Gonçalves, R.C.R. Production of Melanin Pigment by Fungi and Its Biotechnological Applications. In Melanin; Blumenber, M., Ed.; IntechOpen: London, UK, 2017; p. 3760. [Google Scholar]
- Parmar, R.S.; Singh, C. A comprehensive study of eco-friendly natural pigment and its applications. Biochem. Biophys. Rep. 2018, 13, 22–26. [Google Scholar] [CrossRef]
Publisher’s Note: MDPI stays neutral with regard to jurisdictional claims in published maps and institutional affiliations. |
© 2021 by the authors. Licensee MDPI, Basel, Switzerland. This article is an open access article distributed under the terms and conditions of the Creative Commons Attribution (CC BY) license (https://creativecommons.org/licenses/by/4.0/).